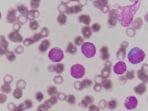

TOPIK
Tips Kesehatan
-
Daun dari pohon eucalyptus dikeringkan, dihancurkan, dan disuling untuk menghasilkan minyak esensial.
-
Leukemia termasuk penyakit akut atau menahun karena adanya satu tipe leukosit tidak matang yang berkembang biak.
-
Buah mangga merupakan salah satu buah-buahan yang digemari karena rasanya yang manis dan segar.
-
Istilah osteoartritis dalam dunia medis memiliki arti terkait kelainan sendi yang kronis.
-
Kurma juga tinggi antioksidan, yang dapat berkontribusi banyak manfaat kesehatannya
-
Kickboxing juga menjadi satu di antara olahraga yang kini disukai oleh anak muda.
-
Berasal dari tumbuhan Coriandrum Sativum, ketumbar masih satu kelompok dengan peterseli, wortel, dan seledri.
-
Meski air hangat bukan yang paling enak, ada banyak alasan untuk mulai rutin minum air putih hangat setiap pagi.
-
Jika mengonsumsi telur sesuai dengan kebutuhan, maka akan dijumpai beberapa manfaat yang baik bagi tubuh.
-
Berasal dari tumbuhan Coriandrum Sativum, ketumbar masih satu kelompok dengan peterseli, wortel, dan seledri.
-
Meskipun masam, ternyata belimbing wuluh menyimpan banyak manfaat. Sementara itu dalam farmakologi China, tanaman ini dikenal memiliki banyak khasiat.
-
Tetapi juga memiliki fitur yang menghibur dan menghindarkan penggunanya agar tidak ketinggalan informasi.
-
Ada beberapa hal yang perlu diperhatikan untuk menjaga tubuh tetap sehat saat musim hujan.
-
Berikut ini manfaat buah jeruk untuk kesehatan, bisa meningkatkan imunitas hingga mencegah asma.
-
Seseorang bermental sehat juga bisa memanfaatkan kemampuan serta potensinya untuk menghadapi segala rintangan dalam hidup.
-
Untuk gejala diabetes yang umum adalah kelelahan, penurunan berat badan, haus yang berlebihan, hingga sering buang air kecil.
-
Satu di antaranya adalah dapat menjaga kesehatan organ vital baik pada laki-laki ataupun perempuan.
-
Jika kamu seorang pekerja yang mengharuskan untuk terus melihat layar komputer, Anda mungkin saja pernah mengalami mata lelah?
-
Nyeri atau kram di perut saat haid itu kerap kali membuat Anda kesakitan meski sudah beristirahat.
-
Ternyata sangat mudah untuk memperbaiki aroma pernapasan yang kurang sedap sekaligus menjaga kesehatan gigi dan gusi.
-
Virus penyebab sakit flu ini juga bisa menyebabkan kondisi kesehatan lain seperti infeksi sinus, telinga, pneumonia, dan sepsis.
-
Air kelapa mengandung vitamin C, asam nikotinat, asam pantotenat, biotin, riboflavin, dan asam folat.
-
Sebagai contoh, seseorang bisa memiliki mata merah ketika mata terasa lelah karena terlalu lama melihat layar ponsel atau komputer.
-
Sebagaimana diketahui, migrain bukan termasuk sakit kepala biasa, namun bisa dialami oleh siapa dari berbagai usia.
-
Selain itu, kemangi juga mengandung antioksidan, yang menjadikannya satu diantara bahan untuk mengatasi berbagai masalah kulit.
-
Satu di antara masalah kesehatan yang sering dialami orang-orang adalah sakit punggung.
-
Ada banyak hal yang menjadi penyebab infeksi sinus, yaitu karena alergen indoor dan juga outdoor.
-
Satu di antara masalah kesehatan yang sering dialami orang-orang adalah sakit punggung.
-
Sebagaimana diketahui, migrain bukan termasuk sakit kepala biasa, namun bisa dialami oleh siapa dari berbagai usia.
-
Yoga, fisioterapi, pengobatan pereda nyeri, dan akupunktur adalah beberapa cara populer untuk mengatasi nyeri punggung.
© 2025 TRIBUNnews.com Network,a subsidiary of KG Media.
All Right Reserved